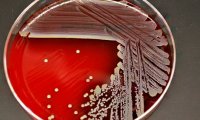
«Неуязвимый» стафилококк добрался до России

На проблемы со здоровьем пожаловались более 500 россиян в Турции
В Роспотребнадзор поступило более 500 обращений россиян в связи с ухудшением здоровья на курортах Турции, среди заболевших наибольшее число составляют дети до 14 лет, сообщили в пресс-службе...